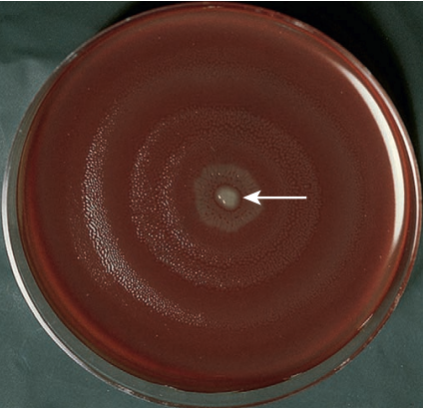
swarm

ASCPi-MICROBIOLOGY
- Description
- Curriculum
- Reviews
-
1HD TUTORIAL - SPECIMEN PROCESSING
-
2PPT - SPECIMEN COLLECTION AND PROCESSING + ASCPi focus Questions
-
3SPECIMEN COLLECTION AND PROCESSING
-
4HD TUTORIAL - BACTERIAL COLONY MORPHOLOGY
-
5COLONY MORPHOLOGY FOR THE IDENTIFICATION OF MICROORGANISMS
-
6HD TUTORIAL BIOCHEMICALS FOR BACTERIAL COLONIES
-
7BIOCHEMICAL IDENTIFICATION OF GRAM-NEGATIVE BACTERIA
-
8ANTIMICROBIAL SUSCEPTIBILITY TESTING
-
9RECORDED - ANTIMICROBIAL SUSCEPTIBILITY TESTING
Antimicrobial susceptibility testing (AST) is performed on bacteria isolated from clinical specimens to determine which antimicrobial agents might be effective in treating infections caused by the bacteria. Only bacteria that are likely to be contributing to an infection should be tested.
Susceptibility testing is usually performed by a disk diffusion or dilution (minimal inhibitory concentration) method.
-
10PPT - COLONY MORPHOLOGY FOR BACTERIAL IDENTIFICATION
-
11HD TUTORIAL VIDEO - STAPHS AND STREPTOS
-
12STAPHYLOCOCCACEAE
-
13HD TUTORIAL - STAPHS AND STREP PLUS ASCPi QUESTIONS
-
14STREPTOCOCCACEAE AND OTHER RELATED ORGANISMS
-
15HD TUTORIAL - ENTEROBACTERIACEAE
-
16ENTEROBACTERIACEAE
-
17HD TUTORIAL - NEISSERIACEAE PATHOGENIC
-
18HD TUTORIAL - MORAXELLA, NON PATHOGENIC NEISSERIA AND HEMOPHILUS
-
19NEISSERIACEAE AND MORAXELLACEAE
-
20HD TUTORIAL - HACEK GROUP OF BACTERIA
-
21HAEMOPHILUS AND OTHER FASTIDIOUS GRAM-NEGATIVE SPECIES
-
22HD TUTORIAL - OTHER FASTIDIOUS GRAM NEGATIVE BACILLI
-
23OTHER FASTIDIOUS GRAM-NEGATIVE BACILLI, BORDETELLA AND LEGIONELLA SPP.
-
24HD TUTORIAL - VIBRIO AND AEROMONAS SPP
-
25HD TUTORIAL - CAMPYLOBACTER + ASCPi QUESTIONS
-
26VIBRIO, AEROMONAS, PLESIOMONAS, AND CAMPYLOBACTER SPECIES
-
27HD TUTORIAL - NON-FERMENTERS G-VE BACILLI
-
28NONFERMENTING GRAM-NEGATIVE BACILLI
-
29HD TUTORIAL - ANAEROBES OF CLINICAL IMPORTANCE
-
30ANAEROBES OF CLINICAL IMPORTANCE
-
31HD TUTORIAL - THE SPIROCHETES
-
32THE SPIROCHETES
-
33THE SPIROCHETES PRACTICE QUESTIONS
-
34HD TURORIAL - CHLAMIDIA AND RICKETTSIA
-
35CHLAMYDIA, RICKETTSIA, AND SIMILAR ORGANISMS
-
36HD TUTORIAL - MYCOPLASMA AND UREAPLASMA
-
37MYCOPLASMA AND UREAPLASMA
Mycoplasmas are the smallest self-replicating organisms in nature.
-
38HD TUTORIAL - MTB AND NTM
-
39MTB AND NTM LESSON 1
MTB and Mycobacterium leprae, the causative agents of tuberculosis (TB) and Hansen disease (leprosy), respectively.
-
40HD TUTORIALS - MTB NTM LAB DIAGNOSIS
-
41MTB AND NTM LESSON 2 - LABORATORY DIAGNOSIS
Rate of growth, colony morphology, pigmentation, nutritional requirements, optimal incubation temperature, and biochemical test results; broth-based culture systems and species-specific nucleic acid probes (PCR) and HPLC are used to identify mycobacteria.
-
42MTB & NTM PRACTICE QUESTIONS
-
43HD TUTORIAL - MEDICAL MYCOLOGY
-
44CLINICAL MYCOLOGY - INTRODUCTION
-
45CLINICAL MYCOLOGY
Mycoses (singular, mycosis) are diseases caused by fungi. Fungal disease is categorized based on the site of the infection—superficial, cutaneous, subcutaneous, and systemic mycoses.
-
46HD TUTORIAL - OPPORTUNISTIC MYCOSES, YEASTS AND MYCOSES LAB DIAGNOSIS
-
47LABORATORY DIAGNOSIS OF FUNGI
-
48HD TUTORIAL - PARASITOLOGY TECHNIQUES AND DIAGNOSTIC PROTOZOLOGY
-
49GENERAL PARASITOLOGY LABORATORY TECHNIQUES
-
50HD TUTORIAL - DIAGNOSTIC PROTOZOLOGY BLOOD AND TISSUE
-
51THE PROTOZOA
-
52THE PHYLUM APICOMPLEXA
-
53HD TUTORIAL - DIAGNOSTIC HELMONTHOLOGY
-
54DIAGNOSTIC HELMONTHOLOGY PART 1
-
55DIAGNOSTIC HELMINTHOLOGY PART 2
-
56HD ASCPi QUESTIONS - MYCOLOGY AND PARASITOLOGY




